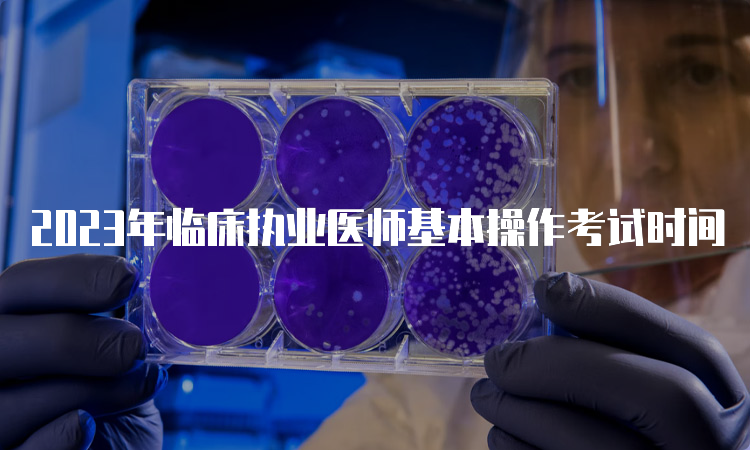

2023年黑龙江临床执业医师实践技能考试时间

2023年河北临床执业医师技能操作考试时间

2023年临床执业医师技能机考部分时间

2023年临床执业医师技能操作考核时间

河北今年临床执业医师实践技能考试时间
2023年临床执业医师基本操作考试时间

2023年四川临床执业医师技能操作考试时间

2023年宁夏临床执业医师技能操作考试时间

2023年临床执业医师分阶段考试操作时间

2023年四川今年临床执业医师实践技能考试时间

2023年临床执业医师分阶段技能考试时间

2023年陕西临床执业医师技能考试时间

宁夏今年临床执业医师实践技能考试时间

2023年河南临床执业医师操作考试时间

2023年临床执业医师第一段考试内容